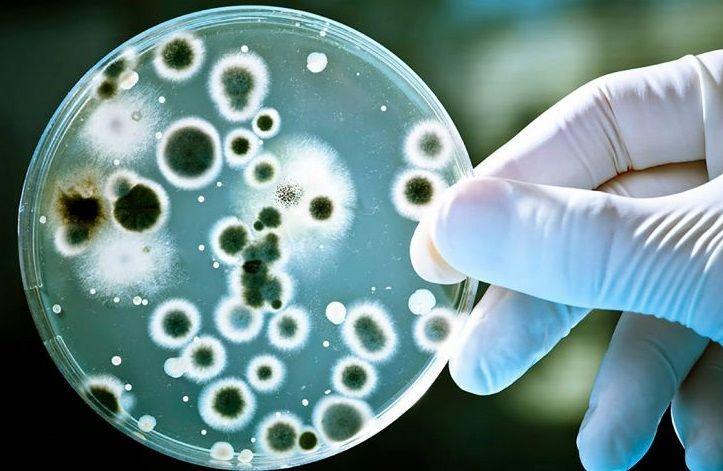

ANMAT prohibió la venta de productos médicos y dio un alerta por botulismo
La Administración Nacional de Medicamentos, Alimentos y Tecnología Médica (ANMAT) prohibió el uso, comercialización y distribución de varios productos médicos.
A través de la disposición 260/2018, publicada...
La OMS se vuelca en evitar 30 millones de muertes en 5 años
La Organización Mundial de la Salud (OMS) publicó su primer plan de inversiones para ayudar a salvar hasta 30 millones de vidas entre 2019 y 2023. De acuerdo con este informe, lograr estos resultados requeriría de...
Steptococcus pyogenes: Son diez las víctimas fatales
El estreptococo o steptococcus pyogenes se cobró nuevas víctimas fatales en distintos puntos del país, entre ellas un nene de Catamarca, un adolescente de Cipolletti y un anciano de Mar del Plata; por lo que ya son...
El sacerdocio en los brazos de la Reina de la Paz
El sacerdocio, en todos sus grados, y por consiguiente tanto en los obispos como en los presbíteros, es una participación del sacerdocio de Cristo que, según la carta a los Hebreos, es el único sumo sacerdote de la...
Streptococcus pyogenes: En CABA habilitan test rápidos y más pediatras en las guardias
Luego de confirmarse la muerte de 6 personas -un adulto y cinco niños- por cuadros invasivos de streptococcus pyogenes alcanzaron pocos días para encender las alarmas del sistema de salud de todo el país y la...
ANMAT retiró más alimentos congelados del mercado
La Administración Nacional de Medicamentos, Alimentos y Tecnología Médica (ANMAT) volvió a retirar del mercado otros tres lotes de alimentos congelados por la presencia de una bacteria.
Esta vez, el organismo...